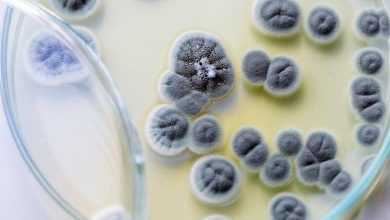

Yeryüzünde birçok hayvan türü insanlar gibi kansere yakalanıyor. Fakat bazı hayvan türleri kanser ile savaşmanın şaşırtıcı yollarını biliyor gibi gözüküyor. Örneğin filler insanlardan trilyonlarca daha fazla hücreye sahiptir ancak kansere yakalanma oranları insanlara oranla çok daha düşüktür. Bu örnek Richard Peto’dan ismini alan Peto paradoksunun da açıkladığı gibi, kanser ile vücut büyüklüğünün bağlantılı olmadığı gerçeğini gözler önüne seriyor.

Kanser, her yıl dünya çapında milyonlarca insanı etkileyen son derece yaygın bir hastalıktır. Dünya Sağlık Örgütü’ne göre, dünya çapında önde gelen ölüm nedenlerinden biridir. Kanserin kesin bir tedavisi hala yoktur. Çok sayıda tedavi seçeneği olmasına rağmen, hayatta kalma oranları genellikle kanserin türüne ve teşhis edildiğinde ne kadar ilerlemiş olduğuna bağlıdır. Kanser araştırmacıları, hastalığın önlenmesi ve tedavisi için yeni yöntemlerin yanı sıra her zaman daha etkili teşhis teknikleri bulmak için de çalışmaktadır.
Bu bağlamda, mavi balinalar ve filler gibi kanserin önemli bir ölüm nedeni olmadığı büyük hayvanların fark edilmesi yeni bir araştırma penceresi açtı. Bu hayvanların bize kanser hakkında ne öğretmesi gerekiyor?
Peto paradoksu nedir?
Peto Paradoksu, adını epidemiyolog Richard Peto’nun adını almıştır. Kendisi farelerde kanserin ilerleme olasılığının bir kanserojene maruz kalma süresiyle ilişkili olduğunu gözlemlemişti. Daha sonra aklına bir soru takılacaktı.
Sonucunda insanların vücudunda farelerden 1000 kat daha fazla hücre bulunmaktadır. Ayrıca farelerden yaklaşık 30 kat daha uzun bir ömre sahiptir. Ancak yine de küçük farelerle benzer bir kanser geliştirme olasılığı bulunmaktadır. Tersine, büyük gövdeli, uzun ömürlü hayvanların kanser riski farelere veya insanlara göre daha düşüktü.

Oysa ki, büyük gövdeli ve uzun ömürlü canlıların daha fazla vücut hücresine sahip olması ve hücrelerinin daha fazla bölünmesi sebebiyle, bu canlıların kısa ömürlü ve küçük canlılara göre kansere yakalanma riskinin daha fazla olması beklenir. Ancak ömürleri ortalama 80 yıl olan filler ve mavi balinalar bu mantığın yanlış olduğunu kanıtladı. Aslında kanıtlar, daha büyük, uzun ömürlü memelilerin daha az kansere yakalandığını gösteriyor. İşte bu durum Peto paradoksu olarak isimlendirilecekti.
Peto Paradoksu nasıl çözülür?
Richard Peto ortaya attığı paradoksa bir çözüm olarak fillerin, balinaların ve diğer kansere dirençli hayvanların daha büyük, daha uzun ömürlü vücutlara sahip olmaları için belirli kanser baskılayıcı mekanizmalar edinmiş olmaları gerektiğini düşünmüştü. Bu mekanizmalar olmasaydı, bu büyük, uzun ömürlü hayvanlar hızlı bir oranda kanserden ölecekti. Bu nedenle de bu büyük hayvanlar belli bir tür adaptasyon geliştirmişti.

2015 yılında bir ekip, Peto’nun teorisini destekleyen kanıtlar buldu. Asya ve Afrika fillerinin genomunu inceleyen ekip, bu fillerin TP53 adı verilen tümör baskılayıcı genin 20 kopyasına sahip olduğunu keşfetti. TP53 geni, anormal bir hücrenin onarılıp onarılmayacağını veya kendi kendini yok etmeye programlanıp programlanmayacağını belirleyen p53 proteininin üretimi için talimatlar içerir. Hasarlı hücrelerin çoğalmasına izin verilmemesi gerektiğinden, bu karar tümörlerin önlenmesi için temeldir.
Ayrı bir araştırmada da fillerin Lösemi İnhibitör Faktörü (LIF) adlı genin 11 ekstra kopyasına daha sahip olduğu anlaşılacaktı. Bu genin görevi de DNA hasarına yanıt olarak hücre ölümünü teşvik etmekti. Bu araştırmalar, bir filin kansere yakalansa bile nadiren bundan öldüğünü ortaya koyuyordu. Vücutları kanserle savaşmak için farklı savunma mekanizmaları geliştirmişti.
2019’da da bir araştırmacı ekibi, Salt adındaki kambur balinadan deri örnekleri aldı. Onun DNA’sını ve RNA’sını sıraladılar ve sonuçları diğer memelilerle karşılaştırdılar. Buldukları şey balina genomunun özellikle hücre büyümesini, çoğalmasını ve DNA onarımını kontrol eden alanlarının, diğer memelilerden çok daha hızlı evrimleştiği olacaktı. Bu da Richard Peto’nun ortaya attığı fikri destekliyordu.
Sonuç olarak;
Eğer balinalar ve filler kanseri yenebiliyorsa, belki biz de bunu başarabiliriz. Bu nedenle de konu ile ilgili araştırmalar devam ediyor. Teorik olarak, kanser hastaları için fillerdeki süreci taklit edecek ilaçlar üretebileceği düşünülüyor.
Gelecekteki kanser tedavisine bir diğer umut da tüysüz köstebek fareleri. Bu hayvanlar tam bir adaptasyon harikasıdır. Yer altı yaşam tarzına uyum sağlayarak, insanların iletişimle ilişkilendirdiği fiziksel yeteneklerin çoğunu ortadan kaldırmışlardır. Ayrıca kansere karşı da dirençlidirler. Kendilerini bu yazıdan daha detaylı tanıyabilirsiniz. Biyolojileri ile Bizleri Şaşırtan Çıplak Kör Fareler İnsanlığın Umudu Olabilir
Kaynaklar ve ileri okumalar
- Caulin AF, Maley CC. Peto’s Paradox: evolution’s prescription for cancer prevention. Trends Ecol Evol. 2011 Apr;26(4):175-82. doi: 10.1016/j.tree.2011.01.002. PMID: 21296451; PMCID: PMC3060950.
- Peto’s paradox: Why do whales and elephants very rarely develop cancer? Yayınlanma tarihi: 28 Ekim 2022. Kaynak site: Interesting Engineer. Bağlantı: Peto’s paradox: Why do whales and elephants very rarely develop cancer?
- Resolving Peto’s Paradox: Why Aren’t Whales Born With Cancer? Yayınlanma tarihi: 15 Ağustos 2022. Kaynak site: IffScience. Bağlantı: Resolving Peto’s Paradox: Why Aren’t Whales Born With Cancer?
- Vazquez JM, Sulak M, Chigurupati S, Lynch VJ. A Zombie LIF Gene in Elephants Is Upregulated by TP53 to Induce. Apoptosis in Response to DNA Damage. Cell Rep. 2018 Aug 14;24(7):1765-1776. doi: 10.1016/j.celrep.2018.07.042. PMID: 30110634.
- Marc Tollis, Jooke Robbins, Andrew E Webb. Lukas F K Kuderna, Aleah F Caulin, Jacinda D Garcia, Martine Bèrubè, Nader Pourmand. Tomas Marques-Bonet, Mary J O’Connell, Per J Palsbøll, Carlo C Maley. Return to the Sea, Get Huge, Beat Cancer: An Analysis of Cetacean. Genomes Including an Assembly for the Humpback. Whale (Megaptera novaeangliae), Molecular Biology and Evolution. Volume 36, Issue 8, August 2019, Pages 1746–1763, https://doi.org/10.1093/molbev/msz099
Matematiksel